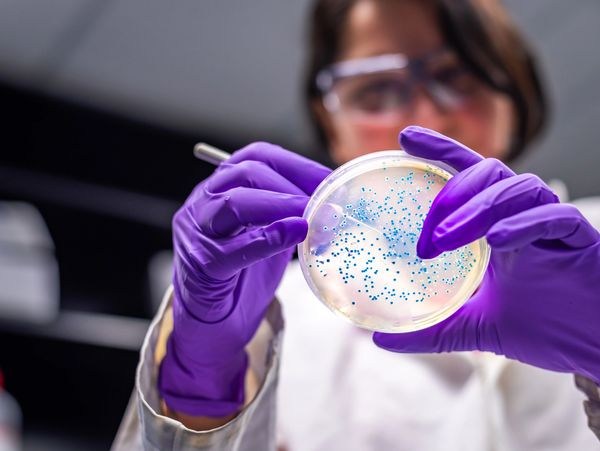

Our Mission
The Martina Borrelli Foundation, all proceeds going towards supporting research in AVM and related neurological disorders.
Martina story

She was beautiful, Strong, and most of all KIND.

She was a Black Belt karate kyokushin

her nickname was "THE MACHINE"

Full of life, with amazing friends and family

Loved her brother Stefano and Nonna famous meatballs

Loved her Brother Stefano

Adored her Dog MYLO

Best thing in a Parents life.

Support Our Cause
Together, we can keep Martina’s spirit alive and bring hope to families impacted by AVM and neurological disorders. We can honor Martina's legacy and help advance vital research that may one day save a child's life and spare families from the pain we live with daily
Contact Us
Martina Belief was to always "be kind"
Martina Borrelli Foundation

This website uses cookies.
We use cookies to analyze website traffic and optimize your website experience. By accepting our use of cookies, your data will be aggregated with all other user data.